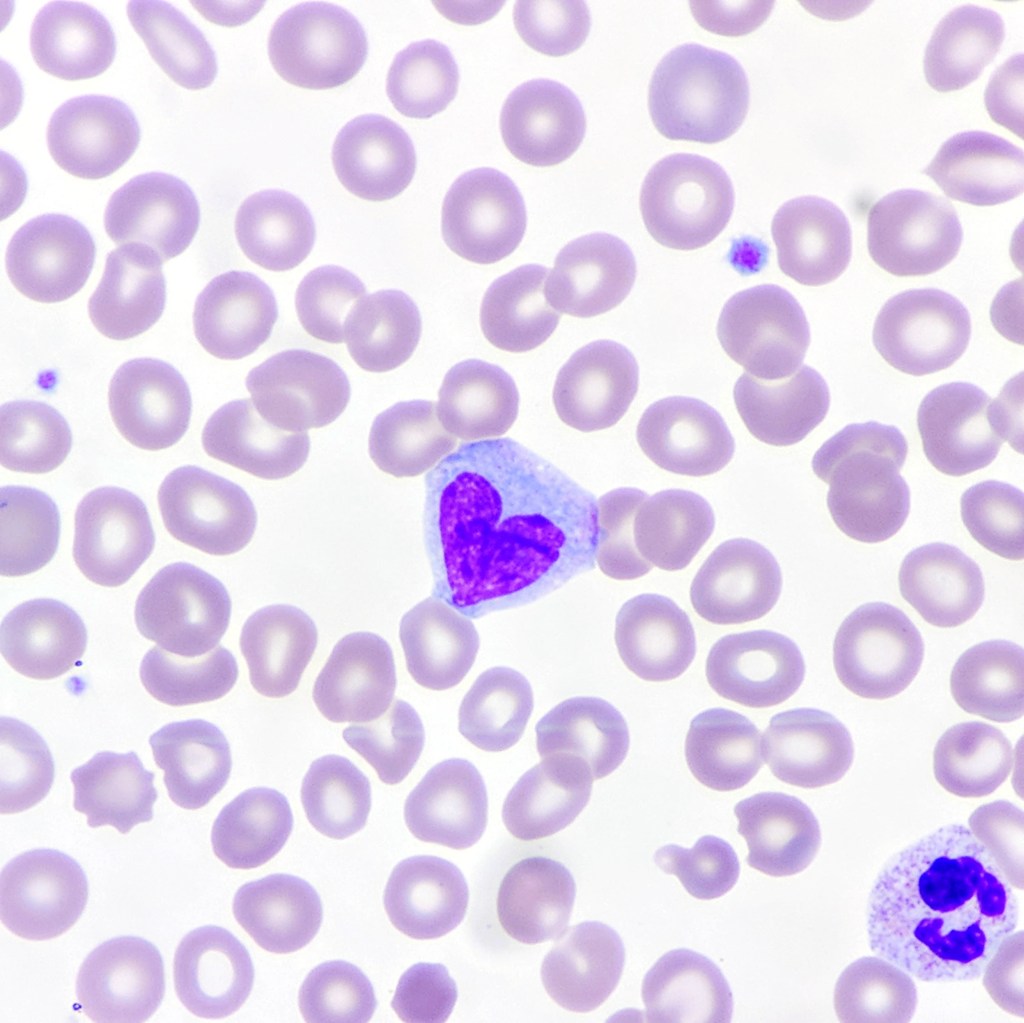

Welcome
“What is Clinical Informatics”
Clinical Informatics is the practice of utilizing data and technology to make medicine better.
A clinical informaticist acts as the bridge between clinical care and information technology.
First time to the site? Start here
From the blog
I finally made it!
As I actively put off board studying for the morning, I wanted to take a moment to pat myself on the back while I sit in my office on my fourth full day as an attending. Or more specifically “Assistant Professor/Clinical”. It has been a full 15 years since I graduated high school to make…
Keep readingData Sharing
One of the biggest challenges of this fellowship has been obtaining data. Being an informatics fellow, data is quite essential to my training. This problem is not unique to me, my current institution or healthcare in general. And it brings me to my next blog topic – data sharing. What is data sharing and why…
Keep readingMy Big Data Failure
As I was thinking about posts to write, I became disappointed about a lost opportunity for a topic due to a personal failure. But then I realized that this failure is as much apart of my journey as my successes. A few months ago, I received a notification that there would be an analytics case…
Keep readingNew posts in your inbox
About Me
I am pathologist. I went to medical school at UNTHSC and then completed my pathology residency at BSW. My training career is a little confusing when it concerns my subspecialty training. Long story short, I have completed fellowships in hematopathology and combined my clinical informatics fellowship (only allowed by the ABP) with a transfusion medicine fellowship that I completed this past year (June 2021). Now, I am a full time clinical informatics fellow at UTHSCSA. Read more